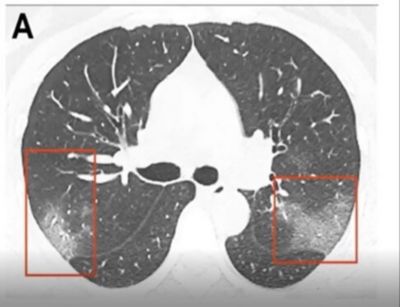

The COVID-19 pandemic left the world, countries, cities, and communities facing uncharted clinical territory. Aside from the pressing need for ventilators globally, Point of Care Ultrasound (POCUS) played, and continues to play, a critical role in supporting the dedicated clinicians serving on the front lines. POCUS has enabled clinicians to quickly and confidently evaluate, assess, and manage patients with a varying level of severity of COVID-19.
Usually, when a patient seeks treatment in the Emergency or Critical Care Department, COVID has progressed to a more advanced stage and time is of the essence.
Imaging COVID-19 Severity in the Lungs
The most common way to look at the chest and lungs is through x-ray and Computed Tomography (CT) imaging. However, for COVID-19, x-rays don’t give you the information needed. The studies that are out, including ones from Lancet, The New England Journal, and the journal Radiology, concluded that due to the low sensitivity and specificity and a broad and varied method of interpreting chest x-rays, the scans tend to be vague. In addition, technicians use non-standard terminology, which can lead to inconsistencies in diagnosis and difficulty in following patients’ progress or decline.

CT is still the gold standard for lung imaging, but it’s difficult to access a CT when you have a critical care patient. The volume of COVID patients, on top of limited access to CT machines, makes this method less than ideal for evaluating the lungs. Interestingly, in about 50 percent of patients, there are no findings between 0-2 days after the onset of symptoms of COVID. It takes about 3-5 days before CT findings are positive. When they are positive, they have bilateral peripheral and basal ground glass opacities (Figure B) in about 50-75 percent of patients. The distribution through the lungs is typically in the lower part of the lungs, but as the disease severity evolves, the CT findings can also be much more extensive.
Ultrasound Imaging Emerging as a Standard
Point of Care Ultrasound (POCUS) is uniquely suited to work in these environments. Pre-COVID, POCUS had gained momentum and appreciated high adoption rates in Emergency Departments due to POCUS’s portability, maneuverability, size, real-time capabilities, ease of use, low cost, and ability to disinfect quickly. POCUS also works well in Critical Care environments. It enables clinicians to image from a patient’s bedside, especially when the criticality of the patients precludes them from being transported for a CT scan. If a COVID patient is transported to the CT suite, that entire CT suite must be disinfected. Some hospitals have dedicated one or two CT suites solely to COVID patients. But doing that may serve as a transmission vector for clinicians and other people in the hospital. Disinfection is difficult and time-consuming for CT suites. When using POCUS on a COVID patient, it is much easier to disinfect one system and a transducer versus an entire room. In addition, POCUS allows the rapid and immediate assessment to evaluate the lungs.
“…the use of ultrasound is now essential in the safe management of the COVID-19 outbreaks, since it can allow the concomitant execution of clinical examination and lung imaging at the bedside by the same doctor.” – Buonsenso D, Pata D, Chiaretti. COVID-19 outbreak: less stethoscope, more ultrasound. Lancet. Mar 20, 2020.
POCUS Applications for Critical Care
POCUS is useful in evaluating the heart, particularly in COVID acute respiratory distress syndrome. Ultrasound imaging at the bedside allows us to assess the heart to determine if the lung changes are related to COVID or an existing disease. Volume assessment may also be utilized in Critical Care to rule out a deep vein thrombosis (DVT) which is particularly useful in larger patients with COVID. In addition, ultrasound is instrumental in placing IV lines.
Figure D. In image D1, the TE7 Ultrasound machine is looking at the inferior vena cava (IVC). Image D2 shows the lung with ultrasound and D3 shows a cardiac assessment with smart measurements to check heart function. Images courtesy of Mindray Medical International.
Lung Ultrasound COVID-19 Findings
Lung ultrasound can help clinicians evaluate respiratory complications. For COVID patients they can track and monitor fluid buildup in the lungs and watch for signs of pneumonia, atelectasis, irregular and thickening pleural lining, or pleural effusions. POCUS can aid clinicians in triaging COVID patients and place them in the best possible care setting based on symptoms and disease progressions – this is usually home care, Critical Care, or the Emergency Room. With Critical Care beds being limited and reaching capacity many times throughout this pandemic, it’s been more important than ever to ensure patients are receiving care in the proper setting.
Ultrasound is a non-invasive imaging method when compared to other imaging modalities. The exams are usually faster, results are real-time, and don’t require fatigued patients to be in uncomfortable positions and settings for imaging. At the Point of Care, POCUS enables real-time results in a variety of settings.
Lung ultrasound’s accuracy in almost all diagnostic testing is measured in terms of its sensitivity and specificity. Due to advances in ultrasound imaging capabilities and technologies, ultrasound exams have proven to be as good, in most cases, at evaluating abnormalities within the lung compared to CT (Figure G). In addition, many POCUS systems now feature new artificial intelligence (AI) enabled tools to simplify workflow, reduce exam times, and ultimately help clinicians increase diagnostic confidence.

Unlike CT, the attending clinician can perform an ultrasound exam several times a day to monitor and track COVID’s progression, as cases tend to evolve rapidly. It is not feasible to do multiple CT scans on a patient throughout the day to check disease severity. With bedside ultrasound, the clinician can assess changes to the patient’s chest and correlate them with changes to the patient’s clinical condition in real-time.
Mindray’s Technology to Help Assess COVID Patients
As Point of Care Ultrasound has emerged as an essential tool to help clinicians assess COVID 19 patients, the need for AI tools became clear. To help clinicians assess, triage, and track COVID patients, Mindray launched new AI-enabled Smart Tools to provide our customers the tools they needed to quickly and accurately evaluate the heart and lungs. These upgrades were provided at no additional cost to our customers so they could have the technologies needed to fight the pandemic. Mindray was uniquely suited to quickly provide these new upgrades due to the power and flexibility of our unique software-based technologies.
Mindray’s POCUS Solutions
Based on clinician and industry feedback, Mindray continues to evolve its comprehensive portfolio of portable ultrasound machines designed to meet a wide range of clinical and financial needs in the battle against COVID. See how innovative, cost-effective, leading-edge ultrasound solutions can empower your clinical team to provide the highest quality of care now and in the future. Experience peace of mind and see something better with Mindray ultrasound.
Disclaimers
*The COVID-19 specific information is based on firsthand information from our colleagues in Shenzhen. Our clinical team worked closely with the practitioners and clinicians in Wuhan, where the pandemic began. This is based on information we have to date; please note, this is still evolving as we learn more about COVID-19.













